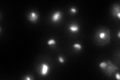
YJL109C

View description
Nucleolar protein, component of the small subunit (SSU) processome containing the U3 snoRNA that is involved in processing of pre-18S rRNA
Localization:
Intensity:
Fold change:
Significance:
-
C’ GFP library in SD
nucleolus111.25 -
N' NOP1pr-GFP in SD

nucleolus101.626 -
N' TEF2pr-mCherry in SD

nucleolus66.3194 -
N' NATIVEpr-GFP in SD

nucleus,nucleolus40.4562 -
N' TEF2pr-VC and Cyto-VN in SD

nucleolus41.1954 -
C’ GFP library in SD+DTT

nucleolusN/AN/ANo -
C’ GFP library in SD+H2O2

nucleolus92.940.83No -
C’ GFP library in Starvation Media

nucleolus51.520.46Yes -
C’ GFP library on the background of Pup2-DaMP

nucleolus -
C’ GFP library on the background of CCT mutant

nucleolus119.7331.07616No
